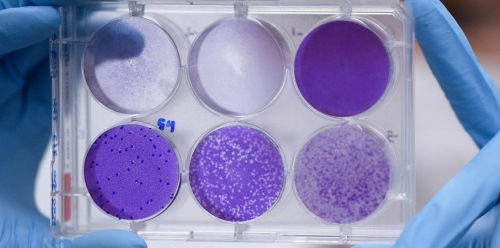

Prefeito tem cinco dias para se manifestar
Pesquisador do Instituto Butantan explica etapas para produção de vacinas e qual a previsão

Atendimento nas creches também seguirá suspenso

O cadastro é obrigatório e todos os profissionais receberão capacitação antes de iniciar o antedimento

Crissiumal teve acumulado entre 45 e 55 milímetros nessa quinta

Proposta foi aprovada nessa quinta

HCC também será beneficiado

Confira as medidas adotadas: